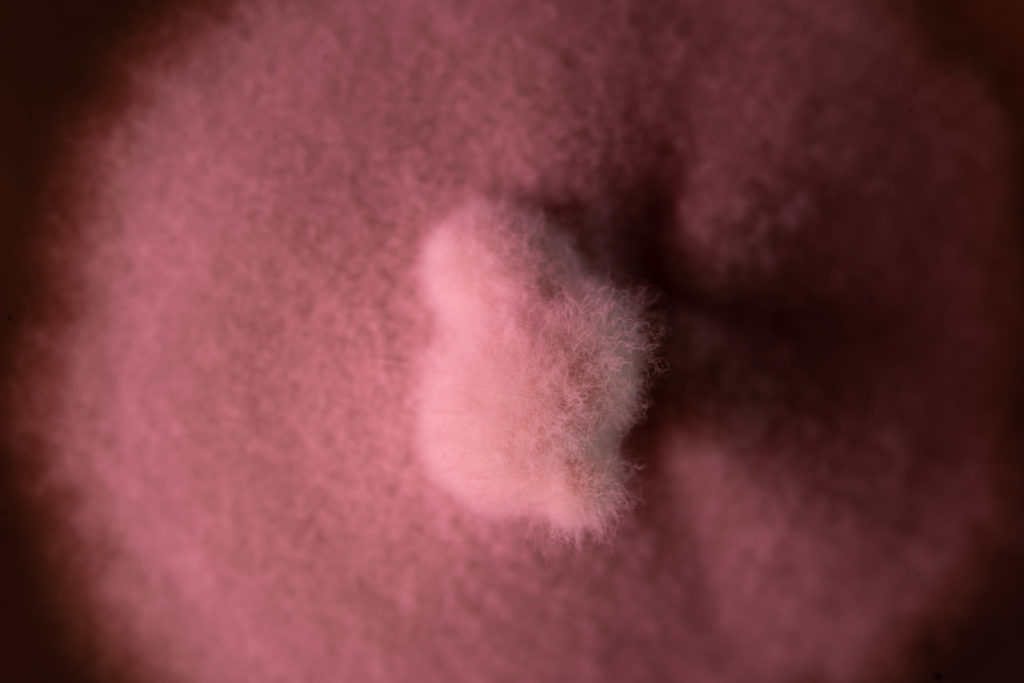

Die Sitzskulpturen von Mathias Garnitschnig sind durch eine künstlerische Auseinandersetzung mit organischen Formen und technischen Infrastrukturen entstanden. Daraus macht der Traditionsbetrieb Gebrüder Zwing ein hochwertiges Polstermöbel. Die Materialien — Lodenstoff aus Italien und Daunenflaum in einem Baumwollinlett aus Österreich – umgeben einen Kern aus Holz und Kaltschaum.


Die Formensprache ist eine Interpretation von nichtmenschlichen Gestaltungsideen, die sich auf modernistischen Oberflächen ausdrücken. Im Biofilm einer Fassade finden wir einen kosmopolitischer Lebensraum, in dem Interessen und Gestaltungsbeiträge verschiedener Spezies auf unvorhersebares Weise zusammen kommen. Dieses Miteinander und Gegenüber vernetzt Weltanschauungen und Wissensformen.
Das Konzept des Tête-à-tête Möbels ist dafür der Ausgangspunkt: eine anatomische Sitz-Struktur, die Dialoge fördert, und ein imaginäres Netzwerk schafft, das alle Skulpturen verbindet.
Formensuche in den Lücken der Moderne
Die Sitzskulptur ensteht in einer Kollaborativen Recherche mit dem Sporadischen Institut an der FH Dornbirn. Das Sporadische Institut erforscht das Umfeld des Gebäudes, um die unbekannten und unsichtbaren Protagonisten kennenzulernen. Dabei entdecken wir fossile Spuren von Lebensformen, die das Erscheinungsbild unserer Welt mitgestalten.
Die Forschungsergebnisse sind die Resultate einer interdisziplinären Zusammenarbeit mit Expert_innen der Universität für Bodenkultur, Inatura, dem Umweltinstitut des Land Vorarlberg sowie unabhängigen Fachleuten.
Aus den Forschungsperspektiven entsteht ein neues Verständnis von Design und Ästhetik. Ausgehend von Materialproben der Fassade wurden Fungi isoliert und kultiviert, durch DNA Extraktion und PCR Tests identifiziert. Neben Fungi leben auf technischen Fassaden auch Algen, Flechten (ein Symbiont aus Pilz und Alge) und Wimpertierchen, die alle in einem Austausch von Nährstoffen stehen.

Im Zwiespalt die Ekstatische Wahrheit
Das Sporadische Institut erzählt Geschichten über Unklarheiten, untersucht den Dreck in den Zwischenräumen der modernistischen Illusion von Klarheit und Produktivität. Es beschäftigt sich mit Wissensformen und Lebensformen die in Lücken und Zwischenräumen existieren, in denen sich Unklarheiten wie der Schmutz auf einer Fassade ansammeln.
Das Institut beschäftigt sich mit der Erhaltung von Wissensformen die von Erneuerungs- und Innovationsprozessen ausgelöscht werden. In den Lücken dieser Auslöschung sammelt sich der Biofilm aus dem zukünftige Forschungsvorhaben entstehen. Auf dem Dreck wächst neues Wissen in neuen Formen.
Das Sporadische Institut öffnet täglich, wenn zwei oder mehr Leute sich auf eine Sitzskulptur treffen und eine Unterhaltung unbestimmten Themas beginnen. Die Themen und Forschungsbereiche des Sporadischen Instituts entstehen sporadisch. Das Institut führt einen wandelnden Katalog des Lückenhaften, von nutzlosem Wissen und unklaren Methoden.
Das sporadische Institut existiert für angewandte Experimente in der Artikulation von Unklarheiten. Das Sporadische Institut sammelt Wissen über die Mit-Gestaltungstätigkeit nicht-menschlicher Wesen.
Das Sporadische Institut entsteht im Rahmen eines Auftrags für ein Kunst und Bau Projekt zur Renovierung und Erweiterung der Fachhochschule Dornbirn und wird vom Land Vorarlberg gefördert und vom Architekturbüro Cukrowicz Nachbaur unterstützt.























